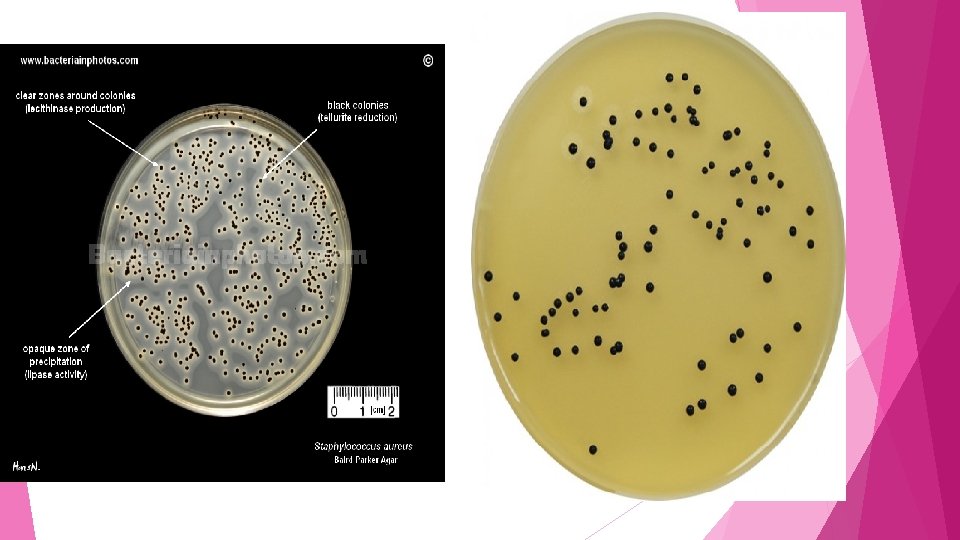

Enumeration of Staphylococcus aureaus in Foods Description v









- Slides: 9

Enumeration of Staphylococcus aureaus in Foods

Description v The method has been shown to produce satisfactory results with naturally-contaminated meats, fish, poultry, vegetables, cereals and dairy products, and artificially-contaminated foods. This method can be used successfully for the detection of Staphylococcus aureus in other foods, food ingredients and environmental samples.

Principle Certain staphylococci produce enterotoxins which cause food poisoning. This ability to produce enterotoxins, with few exceptions, is limited to those strains that are coagulase-positive, and/or produce a heat-stable nuclease (TNase). This method determines the presence of S. aureus by plating known quantities of (dilutions of) a food sample onto a selective agar. After incubation, presumptive staphylococcal colonies are selected, and subjected to confirmatory tests. From the results of these tests, the number of S. aureus per g or m. L of the food is calculated. The numbers present may indicate a potential for the presence of enterotoxin, or they may also indicate a lack of adherence to Good Hygienic Practices.

Detection and Enumeration of S. sureus in food samples Baird-Parker (BP) agar base It is a selective medium for the isolation and presumptive identification of coagulase-positive staphylococci. This medium is used extensively for detecting Staphylococcus aureus in foods, dairy products, and other materials. Coagulase-positive staphylococci can grow and reproduce in cosmetic products. These products are tested for the presence of coagulase-positive staphylococci using standard microbiological methods

Formula / Liter Enrichment Enzymatic Digest of Casein. . . . 10 g Beef Extract. . . . . 5 g Yeast Extract. . . . . 1 g Lithium Chloride. . . . . 5 g Glycine. . . . . . 12 g Sodium Pyruvate. . . . . 10 g Agar. . . *17 g *15 - 20 g according to gel strength Enrichments Chicken egg yolk & egg, 50% Tellurite Supplement (1%) Or Egg Yolk Tellurite, 100 m. L (Chicken egg yolk and egg, 100%) (Potassium Tellurite, 0. 21 g) Final p. H: 7. 0 ± 0. 2 at 25°C

Enzymatic Digest of Casein and Beef Extract are the carbon and nitrogen sources in Baird Parker Agar. Yeast Extract supplies B-complex vitamins that stimulate bacterial growth. Glycine and Sodium Pyruvate stimulate growth of staphylococci. The selectivity of the medium is due to Lithium Chloride and a 1% Potassium Tellurite Solution, suppressing growth of organisms other than staphylococci. The differentiation of coagulase-positive staphylococci is based on Potassium Tellurite and Egg Yolk Emulsion. Staphylococci that contain lecithinase break down the Egg Yolk and cause clear zones around the colonies. An opaque zone of precipitation may form due to lipase activity. Reduction of Potassium Tellurite is a characteristic of coagulase positive staphylococci, and causes blackening of colonies. Agar is the solidifying agent.

Results Examine plates having 20 - 200 colonies, counting colonies typical of Staphylococcus aureus. Coagulase-positive staphylococci produce black, shiny, convex colonies with entire margins and clear zones, with or without an opaque zone. Coagulase-negative staphylococci produce poor or no growth. If growth occurs, colonies are black; clear or opaque zones are rare. The majority of other organisms are inhibited or grow poorly. If growth appears, colonies are light to brown-black, with no clear or opaque zones.

Confirmatory Tests For confirmation of S. aureus, perform the coagulase test as an initial step. Staphylococcal enterotoxin assays, Latex agglutination kits.